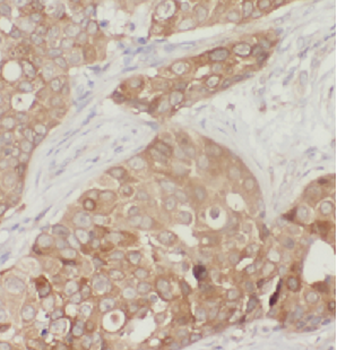
ATF4 Antibody抗体，orb624932，bior

相关产品推荐更多 >
万千商家帮你免费找货
0 人在求购买到急需产品
- 详细信息
- 文献和实验
- 技术资料
- 抗体名:
ATF4 Antibody抗体
- 抗体英文名:
ATF4 Antibody
- 靶点:
ATF4
- 应用范围:
ELISA, IF, IHC, WB
- 宿主:
Mouse
- 适应物种:
Human, Mouse
- 保质期:
6-12个月
- 抗原来源:
详询
- 目录编号:
orb624932
- 级别:
科研级
- 库存:
88
- 供应商:
biorbyt
- 标记物:
Unconjugated
- 克隆性:
Monoclonal
- 形态:
liquid
- 亚型:
IgG1
- 免疫原:
activating transcription factor 4(tax-responsive enhancer element B67)
- 规格:
50 ug
别名:CREB2, TXREB
免疫原:activating transcription factor 4(tax-responsive enhancer element B67)
分子量:50-58 kDa, 35-38 kDa
应用稀释比例:WB: 1:1000-1:2000; IHC: 1:50-1:300; IF: 1:20-1:100
纯度:≥95% as determined by SDS-PAGE
纯化:Protein A+G purified
保存说明:Maintain refrigerated at 2-8°C for up to 2 weeks. For long term storage store at -20°C in small aliquots to prevent freeze-thaw cycles.
UniProt ID:P18848
Note:For research use only.

风险提示:丁香通仅作为第三方平台,为商家信息发布提供平台空间。用户咨询产品时请注意保护个人信息及财产安全,合理判断,谨慎选购商品,商家和用户对交易行为负责。对于医疗器械类产品,请先查证核实企业经营资质和医疗器械产品注册证情况。
文献和实验三句话读懂一篇 CNS:睡不好会缩短寿命,运动可降低风险;压力大的时候,植物也会尖叫
Prev Cardiol 5. J Hepatol:铁死亡在肝细胞癌的发生中发挥重要作用 肝细胞癌(HCC)是癌症死亡的主要原因之一。 2023 年 3 月 28 日,上海中医药大学何锋团队等多个单位共同通讯在 Journal of Hepatology 杂志发表研究论文 ATF4 suppresses hepatocarcinogenesis by inducing SLC7A11 (xCT) to block stress-related ferroptosis。 该研究表明
9.30 兰州大学 Nature 子刊发现共用转录因子调控新机制
反应来响应各种应激信号,该信号转导是协调细胞中蛋白质合成的关键因素。Cao 和他的团队发现,在人的中枢时钟中,压力会导致 eIF2α 的节律性磷酸化,从而促进 ATF4 蛋白的产生。 ATF4 蛋白激活 Per2 基因,最终使时钟转动得更快。他们得出结论,这种机制对于维持稳健的生物钟节律是必不可少的。原文检索:The eIF2α Kinase GCN2 Modulates Period and Rhythmicity of the Circadian Clock by Translational
三句话读懂一篇 CNS:长期玩手机,伤脑又折寿;运动、做家务和社交活动可降低痴呆风险
independently of ATF4。 该研究证明了线粒体蛋白酶 LONP1 对于保持肌肉线粒体蛋白稳态和全身代谢稳态至关重要,揭示了 LONP1 依赖性线粒体蛋白稳态在指导肌肉 UPRmt 调节全身代谢中的关键作用! 图 8:来源 Science Advances 9. Nature:揭示一氧化二氮还原酶的组装过程 一氧化二氮还原酶(nitrous oxide reductase, N2OR)对氧气敏感,其生物合成及组装过程一直尚未明晰。 2022 年 7 月 27 日,德国弗莱堡大学
技术资料暂无技术资料 索取技术资料











